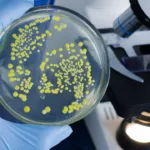
Ukrayna’da “Tedavisi İmkansız” Süper Bakteri

Rekabet Kurumu, Meta Platforms, Inc. (Meta) hakkında başlattığı soruşturmayı, şirketin sunduğu taahhütler doğrultusunda sonlandırma karıarı aldı. Bu karar, Meta’nın Instagram ve Threads arasındaki veri birleştirme politikalarının Rekabetin Korunması Hakkında Kanun’u ihlal ettiği gerekçesiyle başlatılan soruşturmayla yakından ilişkili.
Rekabet Kurumu’ndan Önemli Açıklamalar

Rekabet Kurumu tarafından yapılan açıklamada, Meta’nın Threads uygulamasını Instagram ile bağlantılandırdığı ve iki uygulama arasında veri birleştirmesi yaptığı belirtildi. Bu durumun, kanuna aykırı bir davranış olduğu ve ciddi bir bulgu niteliği taşıdığı değerlendirildi.
Şirketin veri birleştirme politikaları incelendiğinde, şu detaylara dikkat çekildi:
- Instagram’dan toplanan veriler Threads hesaplarına aktarılabiliyor.
- Threads üzerinden toplanan veriler, diğer Meta ürünleri sağlamak, kişiselleştirmek ve iyileştirmek için kullanılabiliyor.
- Meta, bu verilerle şirket ürünlerinin performansını ölçüp analiz ederek kurumsal hizmetler sunuyor.
Bu bulgular, Rekabet Kurulu’nun 20 Ekim 2022 tarihli kararında belirtilen yükümlülüklere aykırı bir davranış sergilendiğini ortaya koydu.
Geçici Tedbirler ve Para Cezası
Rekabet Kurumu, Meta’nın kanuna aykırı davranışlarına karşı geçici tedbir kararlıkları alındığını ve Meta’ya 335 milyon liralık idari para cezası uygulandığını belirtti. Bu kararlar doğrultusunda şirket, Threads’in Türkiye’deki faaliyetlerini askıya aldığını 29 Nisan 2024 tarihinde duyurdu.
Bununla birlikte Meta, ortaya çıkan rekabet karşıtı endişeleri gidermek için Rekabet Kurumu’na yeni çözüm önerileri sundu. Ancak bu öneriler Kurul tarafından yeterli bulunmadı.
Meta’nın Taahhütleri Kabul Edildi

Meta, soruşturmaya konu olan sorunları gidermek amacıyla 30 Ekim 2024 tarihinde Rekabet Kurumu’na bir taahhüt metni sundu. Bu metinde, Threads uygulamasının Türkiye’de yeniden kullanıma sunulacağı ve şu değişikliklerin uygulanacağı belirtilmiştir:
- Threads, Instagram hesabı gerektirmeksizin kullanılabilecek.
- Kullanıcılar, hesaplarını birleştirme tercihinde bulunmadıkça, Threads üzerinden elde edilen veriler Instagram ile birleştirilmeyecek.
Rekabet Kurumu, Meta’nın sunduğu taahhütlerin rekabet sorunlarını giderebilecek nitelikte olduğuna ve etkin bir şekilde uygulanabileceğine karar verdi. Bu nedenle soruşturma, 23 Kasım 2024 tarihli toplantıda 24-45/1053-450 sayı ile sonlandırıldı.
Türkiye’de Yeni Bir Dönem
Meta’nın taahhütleri, hem mevcut hem de yeni kullanıcılar için daha şeffaf bir veri politikasi sunmayı taahhüt ediyor. Bu karar, dijital platformların rekabet kurallarına uyum sağlaması için önemli bir adım olarak değerlendiriliyor. Meta’nın ilerleyen dönemlerde bu yükümlülüklere nasıl uyacağı, piyasa aktörleri ve kullanıcılar tarafından yakından izlenecek.
Meta Açıklamasından Öne Çıkanlar
- Threads, Türkiye’de tekrar kullanıma sunulacak.
- Instagram ile veri birleştirme zorunluluğu kaldırılıyor.
- Kullanıcılar, hesaplarını birleştirip birleştirmemeyi tercih edebilecek.
Meta ve Rekabet Kurumu arasındaki bu sürecin sonuçlanması, Türkiye’deki dijital platform düzenlemeleri için önemli bir emsal oluşturabilir.